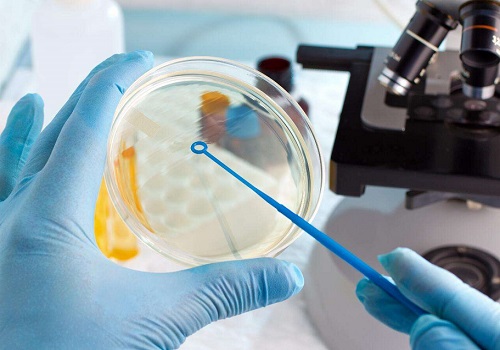
試管可以決定胎兒嗎

首頁 / 試管嬰兒能決定男女嗎 /
首頁 / 試管嬰兒能決定男女嗎 /
試管可以決定胎兒嗎
發布時間:2022-05-12
當代社會,很多的夫妻會使用試管嬰兒去受孕,不知道各位有沒有看過《合約》,電影里面鄭秀文因為對愛情失望但是她又想要一個屬于自己的孩子,她用的就是通過試管嬰兒的方式去受孕。在現實生活中,只要受孕的女方的身體狀況較好,試管嬰兒是可以滿足夫妻雙方想要的想法,接下來,我們一起來看看,試管可以決定胎兒嗎?
試管可以決定胎兒嗎?
試管嬰兒技術的發展只有短短的40年。但是已經經歷了三個階段的突破。第一代試管嬰兒主要針對了女性原因引起的不孕不育;第二代試管嬰兒主要針對的是男性原因引起的不孕不育;第三代試管嬰兒則是針對基因、染色體原因引起的不孕不育。三代試管嬰兒并不是迭代發展的,每一代試管嬰兒都是獨當一面的技術。
那么,試管嬰兒是如何決定胎兒呢?在第一代試管嬰兒和第二代試管嬰兒時期,并沒有準確的的技術。很多時間,為了能夠,往往是移植多顆胚胎,在胚胎成長發育過程中觀察是男是女,從而將另外一個異性“清除”。這種方式是非常危險的,胚胎在成長中被“清除”,另外一顆胚胎也有可能受到影響。所以,這是在極高危險當中。
直到第三代試管嬰兒的出現,準確的技術也就產生了。第三代試管嬰兒技術當中有一種PGD/PGS篩查技術,可以篩查胚胎的染色體、基因。通過對胎兒的Y染色體篩查就可以確定胎兒的了。從而將制定的胎兒移植到子宮中發育成長。這是目前最準確的胎兒選擇的方式。
試管可以決定胎兒嗎?本文講的內容是理論知識,也是實踐的出來的有效的方法。目前PGD/PDS篩查是最好也是最準確的方法。
知識百科
試管嬰兒
美國試管嬰兒
泰國試管嬰兒
X
欧美国产91|
亚洲欧洲在线免费|
欧美日韩高清不卡|
日本久久一区二区三区|
一区av在线播放|
亚洲免费观看在线视频|
国产精品传媒在线|
国产精品免费久久久久|
玖草视频在线|
亚洲精品aaaa精品|
97超碰色婷婷|
久久久伊人欧美|
色中色综合影院手机版在线观看|
久久天天躁狠狠躁夜夜爽蜜月|
中文字幕精品网|
一区二区中文字幕|
中文字幕日韩免费视频|
一区二区三区动漫|
色综合伊人色综合网站|
精品国产欧美一区二区三区成人|
在线观看亚洲视频|
色播久久人人爽人人爽人人片视av|
一二美女精品欧洲|
日韩在线观看网址|
久久手机精品视频|
精品中文字幕在线2019|
久久久久久12|
欧美一级高清免费|
亚洲天堂久久久|
热99re久久精品这里都是免费|
欧美黄色免费视频|
国产精品美女一区二区视频|
久久91av|
2021av网|
日本视频三区|
亚洲欧美一区二区三区在线播放|
欧美女优在线|
麻豆视频在线|
成人高潮aa毛片免费|
日韩激情电影免费看|
欧美日韩五码|
少妇久久久久久|
91麻豆精品国产91久久久久久|
337p亚洲精品色噜噜|
精品久久国产字幕高潮|
亚洲国产精品一区二区久|
日韩精品中文字幕在线播放|
一区二区三区四区精品|
欧美老女人性视频|
97精品国产91久久久久久|
亚洲色图 欧美|
66av国产|
中国免费黄视频|
久久久久久五月天久久久久久久久|
免费av在线电影|
精品孕妇一区二区三区|
国产乱码午夜在线视频|
欧美日韩va|
狠狠一区二区三区|
欧美wwwww|
野花国产精品入口|
国产中文一区二区三区|
久久一留热品黄|
亚洲蜜桃精久久久久久久|
狠狠躁夜夜躁人人爽超碰91|
欧美一区三区二区|
国产一区二区三区精品久久久
|
a级网站在线播放|
日韩电影免费看|
日本精品在线播放|
大色综合视频网站在线播放|
欧美激情久久久久久|
久久久999精品|
久热中文字幕在线|
开心激情五月婷婷|
污导航在线观看|
看女生喷水的网站在线观看|
黑人巨大亚洲一区二区久|
视频精品国内|
欧美电影《睫毛膏》|
午夜在线一区|
成人av午夜影院|
亚洲精品国产无天堂网2021|
欧美偷拍一区二区|
精品亚洲男同gayvideo网站|
色综合视频一区中文字幕|
久久亚洲国产成人亚|
中文字幕免费中文|
eeuss影院www在线观看|
成人美女视频|
欧美变态挠脚心|
影音先锋在线一区|
国产成人a级片|
日韩理论片网站|
欧美日韩成人在线|
中文欧美日本在线资源|
中文字幕第一页av|
天天撸天天射|
91网页在线观看|
性欧美freehd18|
狠狠做六月爱婷婷综合aⅴ|
国产麻豆综合|
久久新电视剧免费观看|
五月天欧美精品|
亚洲国产精品高清久久久|
久久久久久久成人|
美女与牲口做爰视频在线观看|
在线观看国产高清视频|
超碰97国产精品人人cao|
日韩成人久久|
亚洲经典在线|
26uuu精品一区二区在线观看|
亚洲444eee在线观看|
精品国产三级a在线观看|
欧美精品午夜视频|
色噜噜在线网|
黄色av网址在线免费观看|
欧洲一级精品|
色偷偷综合网|
国产精品综合av一区二区国产馆|
亚洲三级视频在线观看|
日韩丝袜美女视频|
欧美精品videosex性欧美|
美女翘臀白浆直流视频|
国产女人在线观看|
欧美成人三级|
伊人色**天天综合婷婷|
国产a区久久久|
午夜亚洲国产au精品一区二区|
日韩精品亚洲视频|
日韩av影音先锋|
在线免费看污|
婷婷激情一区|
91精品亚洲|
国产成人高清在线|
狠狠久久亚洲欧美专区|
蜜臀va亚洲va欧美va天堂|
另类成人小视频在线|
中文字幕制服丝袜一区二区三区|
欧美一卡2卡三卡4卡5免费|
久久久久久久激情视频|
五月亚洲综合|
第一福利在线视频|
国产影视精品一区二区三区|
韩国精品免费视频|
欧美日韩国产限制|
色悠悠国产精品|
开心婷婷激情|
日韩三级电影视频|
九九免费精品视频在线观看|
精品一区二区三区日韩|
午夜久久福利影院|
在线精品视频视频中文字幕|
色视频在线免费|
黄网站视频在线观看|
国产一区二区三区不卡av|
青青草97国产精品免费观看无弹窗版|
亚洲免费观看高清在线观看|
亚洲欧美日韩成人|
91九色国产蝌蚪|
看女生喷水的网站在线观看|
免费看成人哺乳视频网站|
国产中文一区二区三区|
91国模大尺度私拍在线视频|
欧美疯狂做受xxxx高潮|
嫩草视频在线观看|
www.国产精品|
亚洲综合欧美|
亚洲国产一区二区视频|
最新国产成人av网站网址麻豆|
黄色小视网站|
激情aⅴ欧美一区二区欲海潮|
日韩夫妻性生活xx|
久草在线免费福利|
国产v日韩v欧美v|
91精品国产91久久久久久黑人|
91免费视频大全|
欧美mv日韩mv|
国产高清大尺度一区二区不卡|
欧美成年黄网站色视频|
中国av一区|
99精品国产热久久91蜜凸|
91精品国产综合久久久蜜臀粉嫩
|
欧洲亚洲精品视频|
日韩欧美一级|
精品无人码麻豆乱码1区2区
|
亚洲同性gay激情无套|
亚洲成人网久久久|
夜夜夜操操操|
caoporn视频在线|
狠狠入ady亚洲精品经典电影|
日韩一区欧美一区|
色香阁99久久精品久久久|
三级短视频在线|
97人人做人人爽香蕉精品|
在线综合欧美|
亚洲成人av电影在线|
欧美日韩成人黄色|
夜色资源站国产www在线视频|
伊人久久影院|
成人免费观看视频|
精品久久久久久无|
美国做受三级的视频播放|
欧美日韩国产观看视频|
国产欧美欧美|
欧美性色xo影院|
中文字幕高清av|
二区三区在线观看|
综合激情视频|
亚洲一区二区三区自拍|
欧美国产中文字幕|
久久久久久久久国产精品|
国产亚洲成精品久久|
成人狠狠色综合|
国产精品99久久免费|
国产真实精品久久二三区|
日韩一二在线观看|
www.91视频|
免费成人美女女|
老司机精品视频导航|
欧美肥妇毛茸茸|
人人干人人草|
99久久婷婷国产综合精品首页|
六月丁香婷婷久久|
欧美成人在线直播|
eeuss鲁丝片eeuss影院|
亚洲我射av|
成人精品国产免费网站|
日韩av在线网|
黄色一级片视频|
天海翼精品一区二区三区|
久久久99免费|
精品国内亚洲在观看18黄|
羞羞视频在线免费看|
国产精品自拍区|
亚洲欧美日韩国产中文在线|
欧美黑人巨大xxx极品|
无遮挡动作视频在线观看免费入口|
天天超碰亚洲|
午夜私人影院久久久久|
四虎影院影音|
色多多在线观看|
久久精品国产成人一区二区三区|
日韩欧美一区在线|
蜜桃av麻豆av天美av免费|
91九色鹿精品国产综合久久香蕉|
99r国产精品|
久久综合88中文色鬼|
成人三级黄色免费网站|
欧美午夜不卡|
欧美色图第一页|
黑人巨大40cm重口|
日韩中文字幕视频网|
国产婷婷色一区二区三区|
欧美成人h版在线观看|
日本三级视频在线播放|
日韩视频一区二区三区在线播放免费观看|
在线影院国内精品|
人人影院免费大片|
亚洲2区在线|
欧美高清在线精品一区|
欧美劲爆第一页|
欧美bbbxxxxx|
麻豆国产欧美日韩综合精品二区|
亚洲国产成人久久综合|
导航福利在线|
好看的av网站|
全色精品综合影院|
欧美91大片|
欧美三级电影一区|
蜜桃av网站|
综合综合综合综合综合网|
一区二区三区中文字幕电影|
亚洲综合极品香蕉久久网|
不卡av播放|
99视频国产精品|
久久6免费高清热精品|
av片在线观看|
久久精品国产99久久6|
亚洲性生活视频|
www.国产精品.com|
久久久蜜桃一区二区人|
亚洲福利在线视频|
日韩精品系列|
99热这里只有精品8|
日韩女优视频免费观看|
啊灬啊灬啊灬啊灬高潮在线看
|
超碰在线一区二区三区|
99视频精品全国免费|
在线观看国产日韩|
妞干网2018|
欧美国产美女|
欧美日韩国产成人在线免费|
男人天堂2020|
亚洲网站在线|
精品国产一区二区三区久久影院|
色综合久久网女同蕾丝边|
亚洲国产黄色|
亚洲精品电影在线|
国产精品一区在线看|
日韩国产高清在线|
在线播放日韩精品|
污片视频在线免费观看|
国产a视频精品免费观看|
欧美肥婆姓交大片|
超碰aⅴ人人做人人爽欧美|
久久久不卡影院|
777片理伦片在线观看|
精品三级国产|
亚洲综合激情另类小说区|
外卖gayxxxxgay1|
欧美日韩爱爱|
欧美日韩一区小说|
中文字幕中文字幕在线中文字幕三区|
亚洲激情专区|
亚洲人成电影网站色www|
a视频在线播放|
成人免费黄色在线|
亚洲男人天堂影院|
蜜桃精品一区二区三区|
午夜一区二区三区视频|
四虎永久在线高清国产精品|
欧美成人一品|
日韩av一区二区在线|
拍真实国产伦偷精品|
国产高清在线观看免费不卡|
久久青草精品视频免费观看|
男女啪啪999亚洲精品|
亚洲激情五月婷婷|
h在线观看网站|
一区二区三区在线电影|
亚洲成人a级网|
秋霞午夜在线观看|
成人污视频在线观看|
美女福利视频一区二区|
成人午夜大片|
91黄色小视频|
中文字幕在线视频不卡|
秋霞成人午夜伦在线观看|
欧美大奶子在线|
久久精品国产福利|
亚洲成人综合视频|
gogo高清免费视频|
av成人国产|
久久精品最新地址|
欧美视频免费看|
偷拍日韩校园综合在线|
手机看片1024久久|
久久亚洲视频|
欧美激情免费观看|
久久99成人|
色噜噜夜夜夜综合网|
一级黄色在线|
国产传媒一区在线|
√天堂中文www官网|
欧美三级午夜理伦三级小说|
欧美高清视频一二三区|
亚洲精品承认|
久久综合成人精品亚洲另类欧美
|
中文字幕一区免费在线观看
|
日韩精品中文字幕在线一区|
麻豆网站在线|
久久精品无码一区二区三区|
一个人看免费www视频有多爽|
天天综合一区|
亚洲视频自拍偷拍|
性欧美超级视频|
亚洲国产精品精华液网站|
五月天最新网址|
麻豆精品在线观看|
亚洲日本色图|
奇米狠狠一区二区三区|
日韩一区二区在线观看视频播放|
国产黄a三级三级三级av在线看|
国产亚洲精品久|
japanesexxxx在线播放|
性8sex亚洲区入口|
性色av一区二区咪爱|
日韩欧美中文字幕电影|
精品久久久久久久人人人人传媒|
色女人在线视频|
亚洲视频香蕉人妖|
美日韩在线观看|
国产精品资源网站|
国内精品区一区二区三|
91精品国产福利在线观看麻豆|
中文字幕不卡在线视频极品|
日韩一级特黄|
欧美日本韩国一区|
在线视频国产区|
亚洲欧美日韩国产成人精品影院
|
四虎在线视频|
jvid福利写真一区二区三区|
免费大秀视频在线播放|
久久九九免费|
亚洲天堂久久久|
中文字幕一区二区三区在线视频
|
免费大片黄在线观看|
久久综合影视|
第一站视频久草网|

